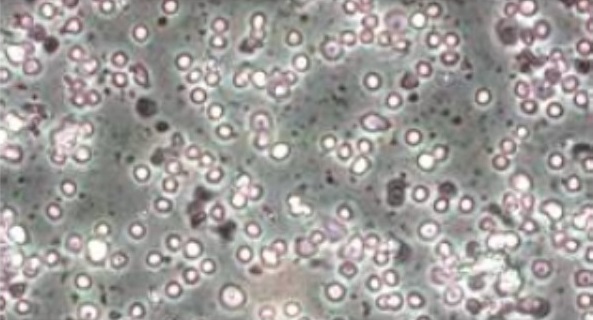
新闻图片3

10 年
手机商铺
入驻年限:10 年
Active Motif
上海 闵行区
试剂、实验室仪器 / 设备、技术服务、抗体
生产厂商 经销商
公司新闻/正文
16494 人阅读发布时间:2019-03-08 15:31
引言
ChIP 实验,简而言之,就是通过富集含有特定蛋白或特定组蛋白修饰的染色质片段,结合后续对纯化的 DNA 片段的检测,获得蛋白质与 DNA 的相互作用的信息,如组蛋白修饰在基因组特定区域的水平及转录因子结合的位点等等,是表观遗传学研究中的常用技术。
获得合适的染色质片段,是 ChIP 实验成功的第一步。目前大多数方法中推荐使用超声破碎仪进行染色质片段化处理,它可以产生随机片段,免去使用酶切反应片段化过程中可能产生某些染色质片段富集引入偏差的疑虑。
1. 超声前准备
首先,您需要准备充足的细胞或组织,一般情况下,细胞量不少于 106,组织样品量在 20~30 mg。ChIP 富集的 DNA 片段少常由起始样本量低及后续反应溶液对样本的过度稀释所造成。
其次,在交联反应过程中,通常使用 1% 的甲醛固定细胞 10 分钟左右(过长的交联反应时间会使细胞形成大的交联聚合物,后续难以超声破碎)。
如果您使用的细胞非常难破碎(如淋巴细胞),可将交联反应时间降至 5 分钟。如果样品需要冷冻,先进行交联反应再冷冻处理。
2. 超声处理优化过程
我们无法为每个品牌的超声破碎仪提供一个相应的标准,因为超声仪的效率要受到仪器的状态和探头使用年限的影响,每一台超声仪都需要进行超声条件的优化操作。
如您使用 Active Motif 的 EpiShear™ 超声仪,我们建议您使用 3.2 mm 的探头和 25% 功率进行染色质超声破碎。

EpiShear™ 超声仪,可固定探头在样品管中的深度,提高超声处理效果的可重复性。
如果您还没有比较成熟的超声条件,可以先从三皿细胞(~4.5ⅹ107)的样品量开始,这样您就有充足的样品量来优化超声条件。可以尝试三种不同的反应条件:如使用 25% 的功率超声 20 秒间歇 30 秒,分别超声 5 次、15 次和 20 次见(图 1),这期间样品一直要置于冰上。

图 1
|
图 1. 电泳分析 HeLa 细胞染色质超声破碎效果 根据 Active Motif ChIP-IT Express kit(Cat# 53008)操作步骤,Hela 细胞用 1% 甲醛固定 10 分钟,3 份 300 μl 样品用 EpiShear™ 超声仪 25% 的功率超声 20 秒间歇 30 秒,分别超声 5 次、15 次和 20 次,纯化后在 1% 的琼脂糖胶上电泳。ChIP 实验一般要求染色质片段在 200~1000 bp 之间(但您若进行 ChIP-seq 实验,根据测序平台通常需要较小的片段)。 Line 1: 100 to 1000 bp Ladder Line 2: HeLa DNA 超声处理 5 次(可用) Line 3: HeLa DNA 超声处理 10 次(可用) Line 4: HeLa DNA 超声处理 20 次(超声破碎过度) 结论:该实验中,样品超声处理 5 次和 10 次比较适合用于 ChIP 实验。 |
3. 改善超声效果的 Tips
(1). 使用较小体积的样品溶液和 V-形底而非圆底管进行超声处理有助于提高染色质片段化的效率。若您使用非接触式超声仪,相比常用的 Polypropylene 材质的 EP 管,Polystyrene 材质的 EP 管超声能量更易穿透,超声破碎效果更好,如 Active Motif 的 Polystyrene Sonication Tubes。
(2). 超声时探头要接近管底但不要碰触到管底和管壁。
(3). 超声前确保您的样品里没有气泡。这一点很重要,因为泡沫或样品乳化会阻碍 DNA 断裂,使染色质片段化不完全。可以通过先使用小功率超声再逐渐增加功率的方法来避免泡沫的产生。如样品溶液已经起泡沫/乳化,可先停止超声,4 ℃ 下 8000 rpm 离心 4 分钟,从而除去气泡。
(4). 超声过程中冰浴间歇的步骤很重要。因为超声脉冲会引起微环境的急剧升温,进而引起蛋白质的破坏/降解,影响后续的免疫沉淀反应。
(5). 如果您的细胞直接超声处理效果较差,可以先使用细胞匀浆器辅助超声破碎。我们建议使用玻璃管与柱塞间距在 0.013~0.064 mm 的玻璃细胞匀浆器,如 Active Motif 的 40401(1 mL)和 40415(15 mL)。这一规格的匀浆器是专门设计用于机械破碎细胞膜的,匀浆后细胞核仍保持结构完整。充分的细胞裂解处理有助于获得更多的染色质片段,匀浆效果可通过显微镜下检测细胞裂解状态。
图 2. 匀浆器处理后显微镜下检测细胞裂解